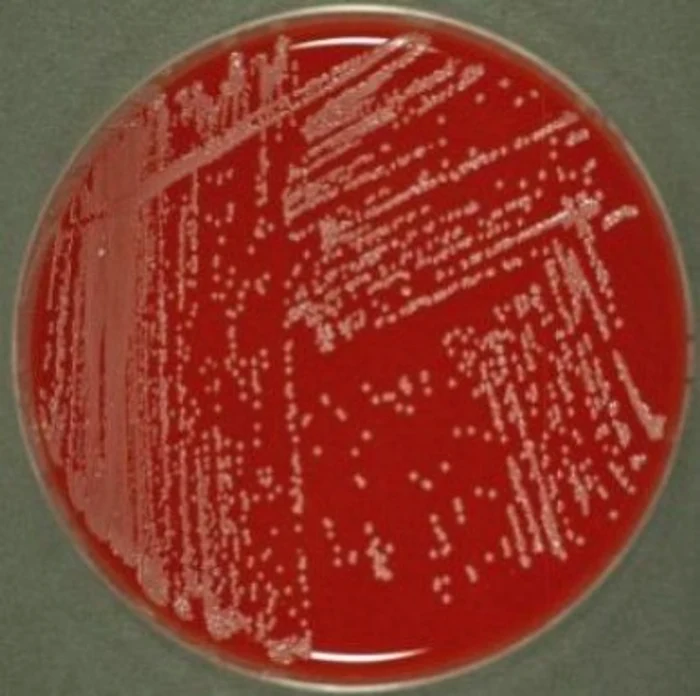
1 2 jpg jpeg

A crescut rezistenţa bacteriană la antibiotice
Cu prilejul întâlnirii de astăzi, la care au participat reprezentanţii Institutului Naţional de Boli Infecţioase, a Societăţii Române de Microbiologie şi a companiei Houston NPA, s-a atras atenţia asupra rezistenţei bacteriene la antibiotice.
În ultimii ani, bacteriile Acinetobacter spp au prezentat o imunitate mai mare la carbapeneme, antibioticele de rezervă extrem de importante pentru infecţiile determinate de unii bacili gram-negativi cum ar fi Pseudomonas aeruginosa, Acinetobacter sau Enterobacteriaceae. Prin urmare, Centrul European pentru Controlul Bolilor Transmisibile a decis încă din anul 2012 ca Acinetobacter spp să fie inclus în lista cu bacterii supravegheate în cadrul reţelei EARS-Net.
Favorizează apariţia infecţiilor intraspitaliceşti
determină infecţii nosocomiale, adică acele infecţii intraspitaliceşti, care se adaugă bolii pentru care pacientul s-a internat. Infecţiile nosocomiale pot să fie în legătură cu deficienţe de igienă, sterilizare, manevre sau îngrijiri medicale.
Prin pierderea eficienţei carbapenemelor vor fi foarte dificil de tratat pacienţii spitalizaţi. Aceştia vor avea un risc major de evoluţie nefavorabilă în absenţa unui tratament eficient.
Situaţia din România
La nivel naţional, în anul 2012 s-au înregistrat niveluri extrem de ridicate ale rezistenţei la carbapeneme pentru
- 86,3% - şi pentru
, 61,4% (cel mai ridicat între statele europene).
Concluzie: Dintre acţiunile care pot limita acest fenomen care poate avea consecinţe dintre cele mai grave, buna practică a terapiei antibiotice este cea mai importantă. Utilizarea judicioasă a antibioticelor înseamnă a le folosi doar când sunt necesare, în doza corectă (nu subdozate), în ritmul de administrare corect şi pentru durata corespunzătoare (nu prelungit dincolo de acest moment).
























